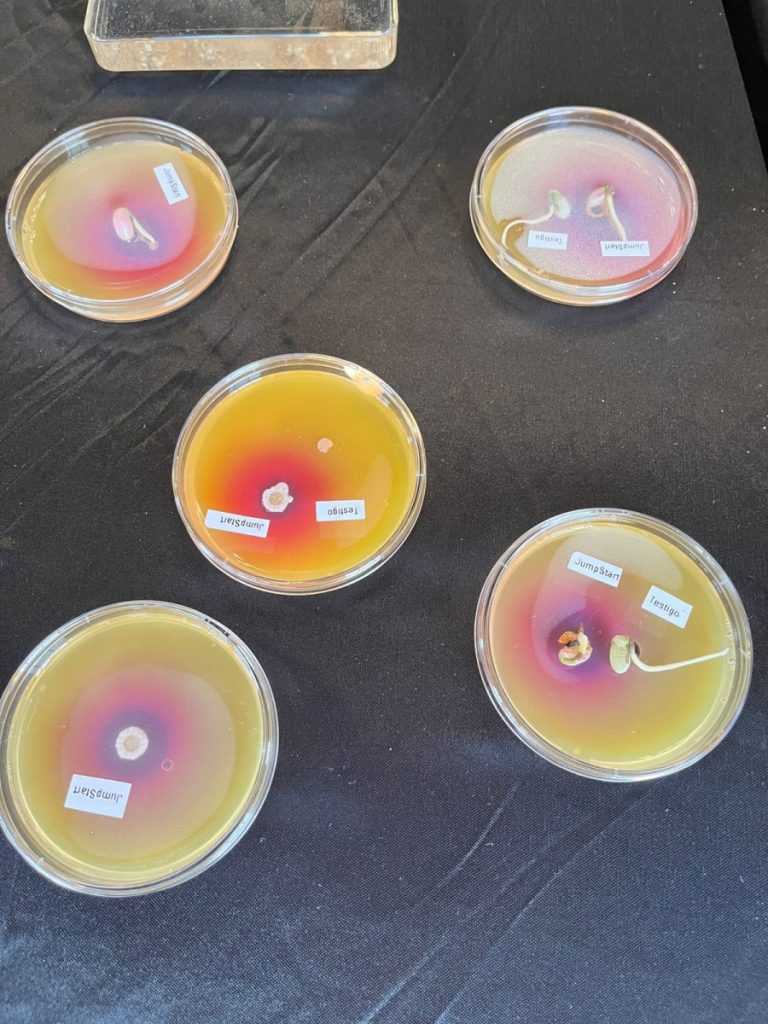
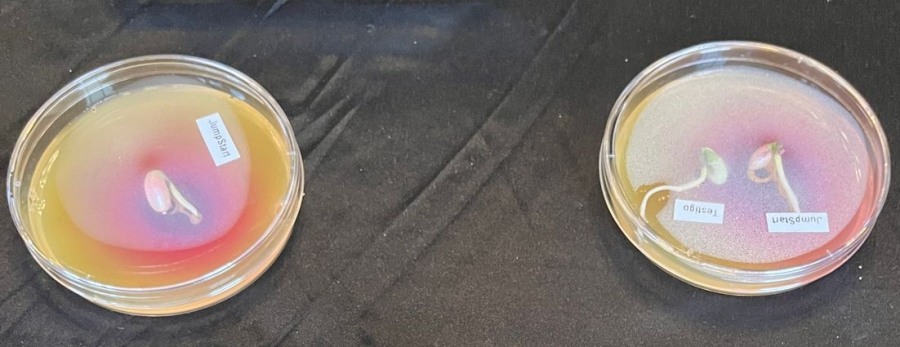
Una nueva combinación de microorganismos incrementa en doscientos kilos el rendimiento de soja frente a la inoculación tradicional

En el Congreso AAPRESID, Novonesis destacó el poder que los biológicos tienen para aumentar los rendimientos de soja en forma sostenible.
En respuesta a la creciente demanda de prácticas agrícolas más amigables, Novonesis, empresa líder mundial en biosoluciones, desarrolla nuevas formulaciones que potencian los beneficios de los microorganismos en los cultivos agrícolas. La innovación radica en la aplicación de la técnica de coinoculación y por otro, en la calidad de las formulaciones obtenidas.
La inoculación en soja es una práctica ampliamente adoptada, que se basa en la incorporación de las bacterias Bradyrhizobium japonicum al momento de la siembra, con el objetivo de maximizar la fijación biológica del nitrógeno atmosférico. La novedad para la próxima campaña será la posibilidad de aportar al cultivo los beneficios adicionales de Azospirillum argentinense en el tratamiento de semillas, en una única formulación.
Esta bacteria seleccionada para el cultivo de soja, es un promotor del crecimiento que favorece un mayor desarrollo radicular, aumentando la capacidad de exploración del suelo y el aprovechamiento del agua y los nutrientes. Además, tiene efectos positivos en la estructura del suelo y el potencial incremento de materia orgánica, por un mayor volumen de raíces.
Gisela Santella, Gerente de Investigación y Desarrollo de Novonesis, destaca: “Es importante señalar que, una vez aisladas las cepas, la formulación es crucial. No solo es esencial la combinación de los microorganismos, sino también garantizar la sobrevida en el envase para que lleguen al lote en la cantidad y la calidad requerida para cumplir con su acción. En ese sentido, Nitragin Genesis es la formulación que permitirá, a partir de 2025, llevar al lote los beneficios de la coinoculación”.
Los ensayos realizados con Nitragin Genesis en la región pampeana han demostrado incrementos en los rendimientos de soja de hasta un 5% en comparación con los métodos de inoculación convencional, destacando la importancia de esta innovación para la competitividad de los productores sojeros.
Gentileza.- Micaela Sierra Pino